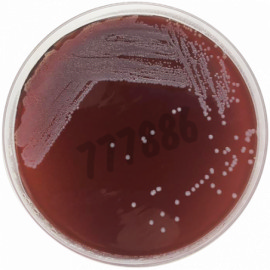
Tryptose blood agar base 500 g

Milieux de bactériologie et additifs
4751 produits - Trié par pertinence
Agar ogye base selon iso pour la microbiologie 500 g
Réf. UGAP : 3735348 Réf. constructeur : 1059780500
Gélose Xylose Lysine Desoxycholate (XLD) BAC ISO-6579 ISO-19250 ISO-21567 500 g
Réf. UGAP : 3712584 Réf. constructeur : AGXL-00I-500
Pseudomonas agar F (base) for microbiology, 500 g
Réf. UGAP : 3735334 Réf. constructeur : 1109890500